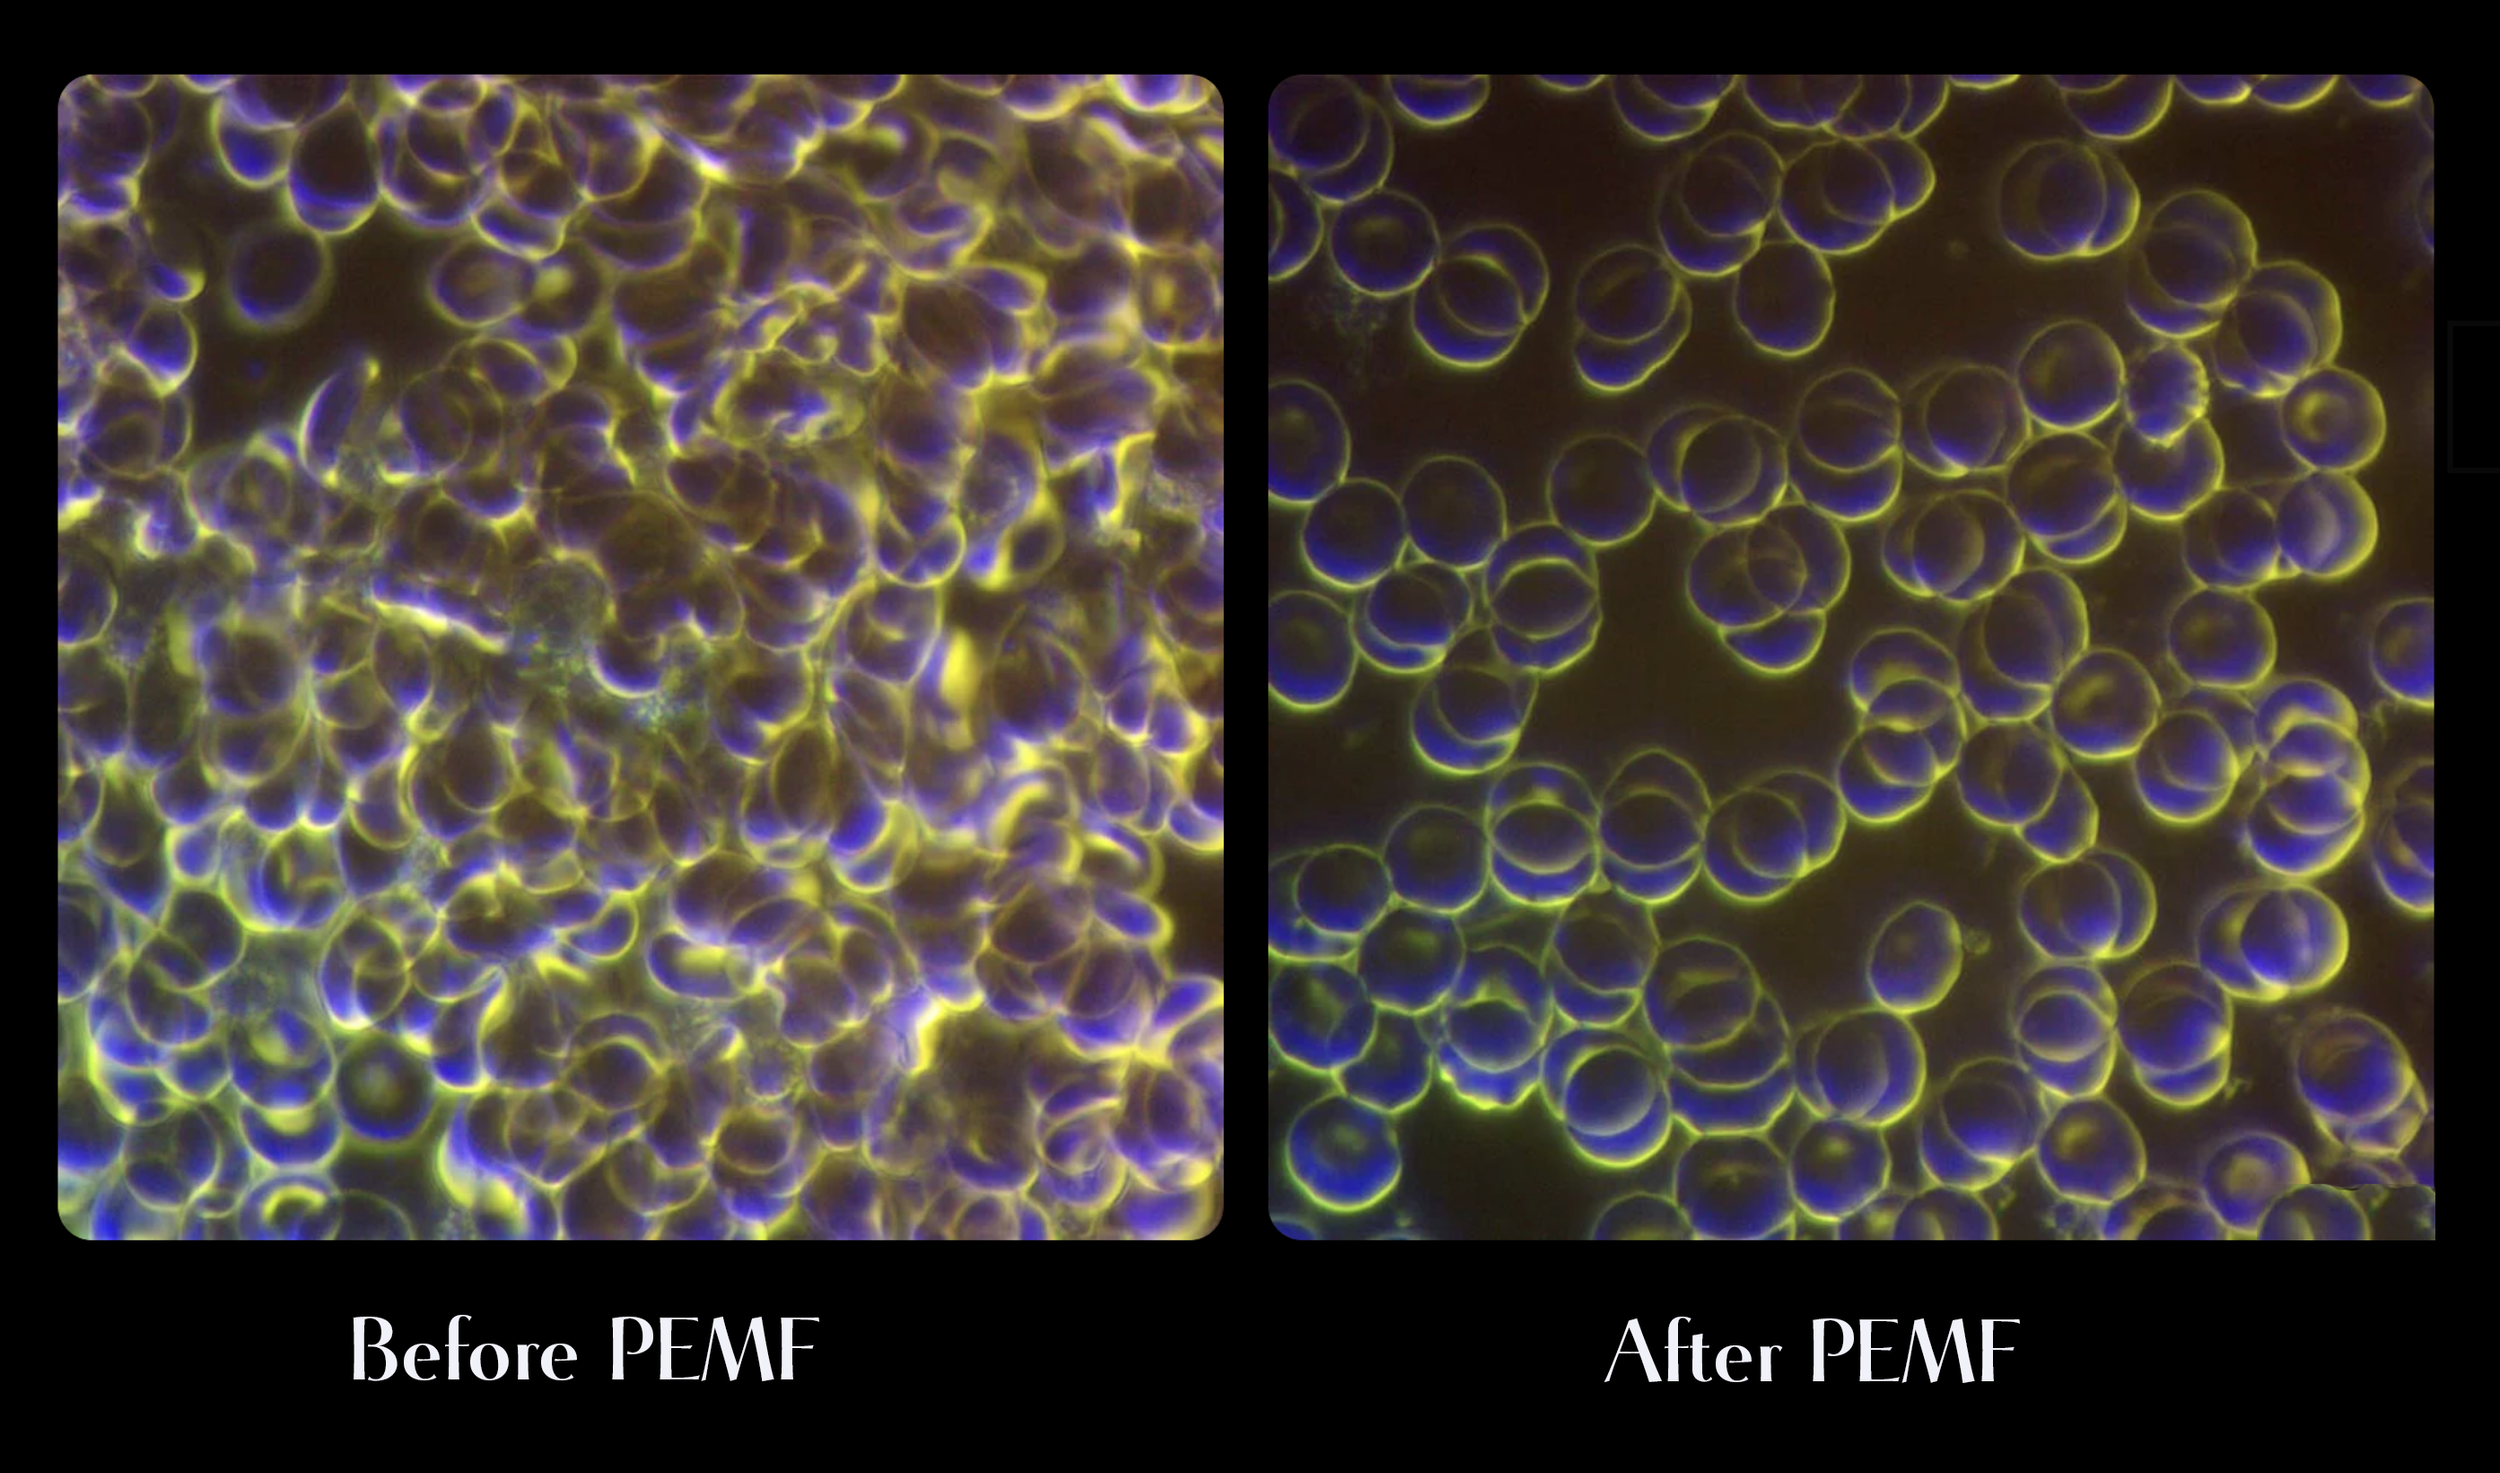

How PEMF & Red Light Therapy Support the Body
At Lumaya, technology is used in a calm, supportive way. PEMF and Red Light Therapy are the tools that create the conditions for rest, regulation, and cellular support.
PEMF- Pulsed Electromagnetic Field Therapy

Pulsed Electromagnetic Field (PEMF) therapy works with the body’s natural electrical communication. Every cell communicates through electrical signals, and PEMF is used to support this process when it becomes sluggish or under strain.
By gently pulsing electromagnetic fields through the body, PEMF supports circulation and cellular function. This assists the movement of blood cells, allowing oxygen and nutrients to be delivered more efficiently and supporting the body’s natural processes of repair and recovery.
What PEMF supports
circulation and blood flow
oxygen and nutrient delivery
cellular communication
nervous system regulation
energy levels
muscle recovery
Red and Blue Light Therapy

At Lumaya, light therapy sessions include red, near-infrared, and blue light wavelengths.
Red and Near-Infrared Light
Red and near-infrared light are absorbed at a cellular level and are commonly associated with supporting:
mitochondrial activity and ATP production
cellular repair and tissue support
skin health and collagen support
recovery and overall vitality
These wavelengths penetrate more deeply into the body and are often used to support regulation and restoration.
Blue Light
Blue light is typically used at a more surface level and is commonly associated with:
supporting skin clarity and balance
maintaining skin health through its antibacterial properties
supporting overall skin hygiene and tone
When used intentionally and in appropriate doses, blue light is included alongside red and near-infrared light as part of a balanced session.
Using PEMF and Red Light Therapy Together

PEMF and light therapy support the body in complementary ways.
PEMF works with the body’s natural electrical communication, supporting circulation, cellular signalling, and nervous system regulation. Light therapy works at a cellular level, supporting energy production within the mitochondria and assisting tissue health and recovery.
When used together, these technologies support both cellular communication and cellular energy, creating conditions that encourage the body to function more efficiently without forcing change.
PEMF helps create flow and coherence within the system, while red, near-infrared, and blue light support cellular processes that rely on adequate oxygen, nutrients, and energy availability.
At Lumaya, these technologies are offered together in a calm, non-stimulating environment. The intention is not to push the body, but to provide steady, supportive input and allow the body’s own intelligence to respond.
Why people choose this combination
People often choose PEMF and light therapy together to support:
circulation and oxygen delivery
cellular energy and repair
nervous system regulation
recovery from stress and fatigue
a sense of balance and vitality
Sessions are designed to feel grounding, restorative, and quietly supportive.
My CELLER8 PEMF mat and my Red Light are sourced from Novumlife Australia and imported from the UK.
The integrity and quality of these products are what appealed to me. After months of research, I was delighted to find CELLER8 PEMF is made with 12 high-quality copper coils and hand-stitched with care.

Important information
PEMF and light therapy are not suitable during pregnancy or for individuals with implanted electronic medical devices such as pacemakers.
If you have questions about whether these sessions are appropriate for you, you’re welcome to get in touch before booking.